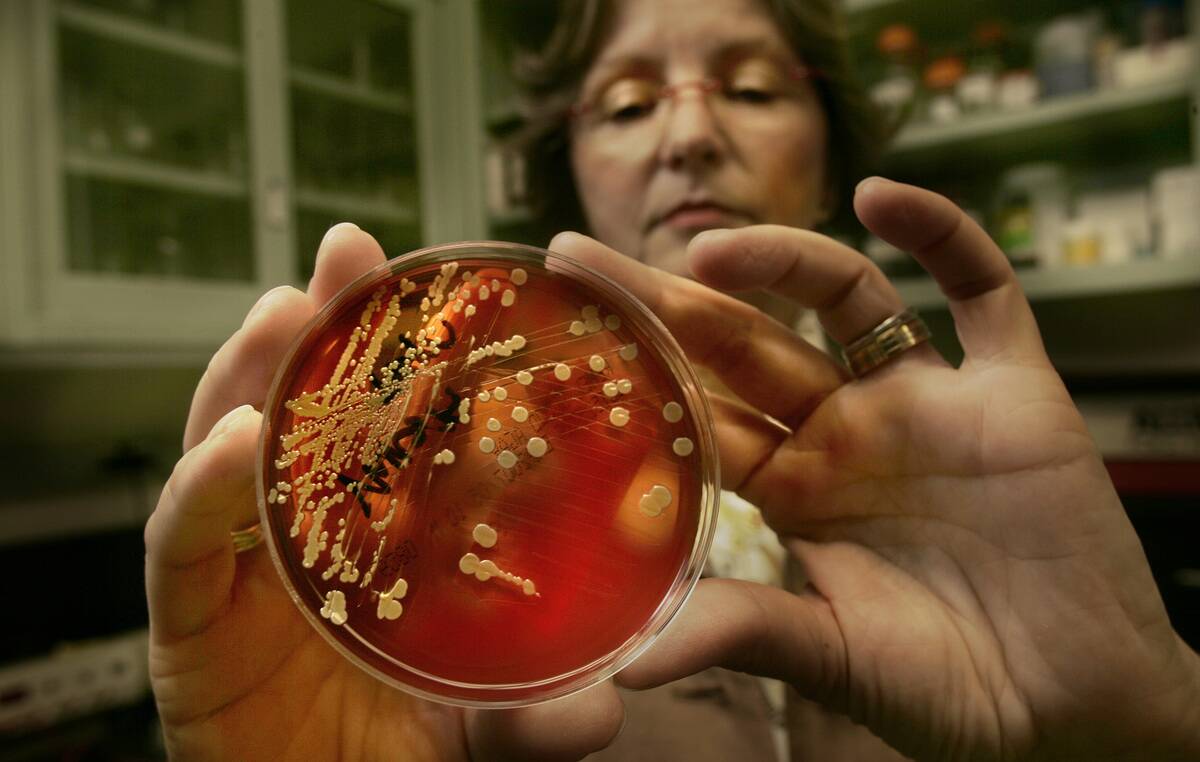
GettyImages-1321911954

The impact of bacteria on indoor air quality
Trending Now
Welcome to the invisible world of bacteria, the tiny titans that thrive in every nook and cranny of our homes. These microscopic creatures are everywhere, from the surfaces we touch daily to the air we breathe.
While the thought of bacteria might send shivers down your spine, it’s fascinating to understand their role in our living environments. Let’s dive into this unseen world and uncover the marvels of these microbial roommates!
Unseen Roommates: Where Bacteria Lurk in Your Living Spaces

You might be surprised to learn that your kitchen sponge holds more bacteria than a toilet seat! Bacteria love damp, warm environments, making your bathroom and kitchen prime real estate.
Even your trusty TV remote is a hotspot, with studies showing it as one of the dirtiest items in the home. So, next time you kick back on the couch, remember these unseen roommates might be more prevalent than you think!
The Science of Air Quality: What Does It Really Mean?

Air quality refers to the condition of the air within our living spaces, and it’s more complex than just being ‘fresh’ or ‘stuffy.’ It includes pollutants like dust, pollen, and, yes, bacteria. Poor air quality can affect health, leading to allergies or respiratory issues.
Understanding the components of air quality helps us make informed decisions about improving it, ensuring our homes are safe and comfortable for everyone.
Meet the Microbes: Different Types of Bacteria Found Indoors

Not all bacteria are created equal! Indoors, you’ll find a mix of good and bad bacteria, each playing its part.
Common types include Staphylococcus, which can be both harmful and harmless depending on its strain, and Lactobacillus, often found in fermented foods.
The Good, the Bad, and the Ugly: How Bacteria Affect Air Quality

Bacteria can be both beneficial and detrimental to our air quality. Beneficial bacteria like Lactobacillus can help break down organic matter, reducing odors and pollutants.
However, harmful bacteria such as certain strains of Staphylococcus can contribute to infections. Maintaining a balance between these organisms is crucial for keeping our indoor air fresh and healthy.
Bacteria and Allergens: A Sneaky Connection
Did you know that bacteria can influence the presence of allergens in your home? Dust mites, which are common allergens, thrive on bacteria-laden dust.
When bacteria break down organic matter, they can release compounds that aggravate allergies. It’s a sneaky connection that makes managing bacteria levels even more important for those with sensitivities.
The Role of Humidity: A Bacteria’s Best Friend or Foe?

Humidity plays a dual role in the life of bacteria. While high humidity can encourage bacterial growth, low humidity levels can dry out and kill some bacteria.
Ideally, maintaining a humidity level between 30-50% keeps the air comfortable and limits dust mites. It’s a balancing act that can significantly impact the microbial population in your home.
Bacteria vs. Mold: The Dynamic Duo of Indoor Air Quality

Bacteria and mold often coexist, impacting indoor air quality in unique ways. While bacteria can contribute to odors, mold is notorious for its musty smell and health risks. Both thrive in moist environments, making regular cleaning and ventilation essential.
Understanding the relationship between these two can help you tackle air quality problems more effectively.
Pets and Their Microbial Contributions to Your Home

Pets bring joy and companionship, but they also introduce a whole new set of microbes into your home. Studies show that homes with pets have more diverse bacterial colonies, which can actually boost immune responses in humans.
However, it’s essential to manage pet dander and shedding to keep both bacteria and allergens in check.
Ventilation: The Unsung Hero in Battling Bacteria

Ventilation is crucial in controlling indoor bacteria levels. By increasing air circulation, you can reduce the concentration of bacteria and other pollutants.
Proper ventilation helps remove stale air and introduces fresh, clean air, making it an unsung hero in maintaining a healthy home environment. So, don’t forget to crack open a window or run a fan to keep your indoor air fresh!
Cleanliness is Next to Healthiness: Simple Steps to Reduce Indoor Bacteria

Keeping your home clean is one of the most effective ways to reduce bacteria. Regularly washing surfaces with soap and water, using disinfectants on high-touch areas, and ensuring proper food storage can significantly cut down on bacterial growth.
By incorporating these simple steps into your cleaning routine, you can create a healthier living space for you and your family.
High-Tech Helpers: Air Purifiers and Their Role in Controlling Bacteria

Air purifiers are a high-tech solution for reducing indoor bacteria. Equipped with HEPA filters, they capture airborne bacteria and allergens, improving air quality. Some models even use UV light to kill bacteria, providing an extra layer of protection.
Investing in a quality air purifier can be a game-changer for those looking to enhance indoor air quality.
Plants: Nature’s Air Filters and Their Impact on Bacteria Levels

Houseplants do more than just beautify your space; they also act as natural air filters. Plants like the spider plant and peace lily can absorb toxins and microbes, including certain bacteria, from the air.
By adding greenery to your home, you not only improve aesthetics but also contribute to a healthier indoor atmosphere.
The Kitchen Conundrum: Bacteria Hotspots in Your Cooking Space

The kitchen is a bustling hub of bacterial activity. Areas like the sink, cutting boards, and countertops can harbor harmful bacteria like E. coli and Salmonella.
Regular cleaning and proper food handling practices are essential to keep these hotspots under control. By staying vigilant, you can ensure your kitchen remains a safe and healthy place for meal preparation.
DIY Solutions: Homemade Remedies to Improve Air Quality

For those who prefer a hands-on approach, DIY solutions can help improve air quality. Simple remedies like baking soda for odor control or vinegar as a natural disinfectant can be effective against bacteria.
Incorporating essential oils with antibacterial properties, such as tea tree or eucalyptus, can also freshen up your space. These homemade hacks offer an affordable and eco-friendly way to enhance indoor air.
Fun Facts: Surprising Truths About the Bacteria in Our Homes

Did you know that a typical human sheds about 1.5 grams of skin each day, feeding millions of bacteria? Or that a single bacterium can multiply into millions within hours under the right conditions?
These tiny organisms are fascinating in their resilience and adaptability, reminding us that our homes are part of a much larger microbial world. Embracing these truths can make the invisible world of bacteria a little less daunting.